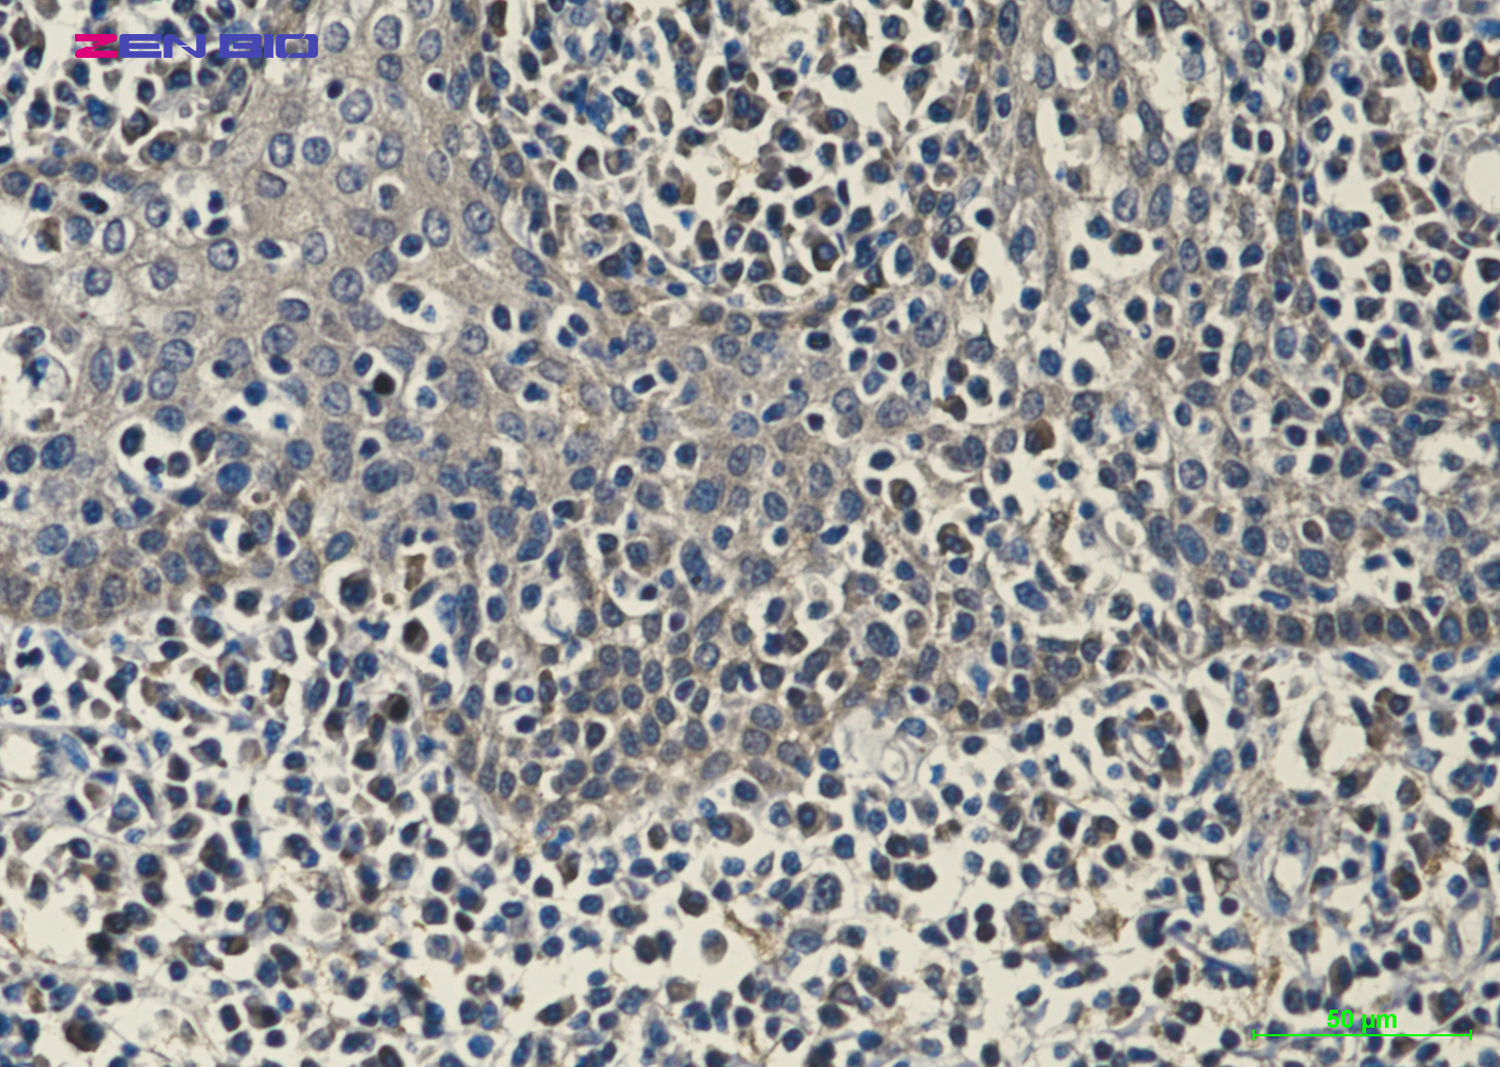

单克隆抗体
Progesterone Receptor (8H3) Mouse mAb (AB3455)
UniProt:P06401
Application:IHC,ICC/IF
Reactivity:Human,Mouse,Rat
Source:Mouse mAb
Progesterone Receptor (8H3) Mouse mAb (AB3455)
UniProt:P06401
Application:IHC,ICC/IF
Reactivity:Human,Mouse,Rat
Source:Mouse mAb
http://www.abways.cn/showproduct.asp?cid=AB3455
beta III Tubulin (3H2) Mouse mAb (AB3456)
UniProt:Q13509
Application:WB
Reactivity:Human,Mouse,Rat
Source:Mouse mAb
beta III Tubulin (3H2) Mouse mAb (AB3456)
UniProt:Q13509
Application:WB
Reactivity:Human,Mouse,Rat
Source:Mouse mAb
http://www.abways.cn/showproduct.asp?cid=AB3456
alpha smooth muscle Actin (3G2) Mouse mAb (AB3457)
UniProt:P62736
Application:WB,IHC,ICC/IF
Reactivity:Human,Mouse,Rat
Source:Mouse mAb
alpha smooth muscle Actin (3G2) Mouse mAb (AB3457)
UniProt:P62736
Application:WB,IHC,ICC/IF
Reactivity:Human,Mouse,Rat
Source:Mouse mAb
http://www.abways.cn/showproduct.asp?cid=AB3457
GAP43 (10C7) Mouse mAb (AB3458)
UniProt:P17677
Application:WB,IHC
Reactivity:Human,Mouse,Rat
Source:Mouse mAb
GAP43 (10C7) Mouse mAb (AB3458)
UniProt:P17677
Application:WB,IHC
Reactivity:Human,Mouse,Rat
Source:Mouse mAb
http://www.abways.cn/showproduct.asp?cid=AB3458
Peroxiredoxin 1/PAG (6A6) Mouse mAb (AB3459)
UniProt:Q06830
Application:WB,IHC,ICC/IF
Reactivity:Human,Mouse,Rat
Source:Mouse mAb
Peroxiredoxin 1/PAG (6A6) Mouse mAb (AB3459)
UniProt:Q06830
Application:WB,IHC,ICC/IF
Reactivity:Human,Mouse,Rat
Source:Mouse mAb
http://www.abways.cn/showproduct.asp?cid=AB3459

销售咨询
销售咨询 一键电话
一键电话